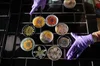

Nicholas Hall Gallery Overview 2025






Lynsey Robertson - "Daddy" - 2025

Em Joseph - Making Eggs with Storyteller - 2023








Documentation for Sally Jerome







Documentation for Lauren Portada

Documentation for Gold Scopophilia

Documentation for Gold Scopophilia

Documentation for Dominic Musa

Documentation for Sallie Jerome

Frances Chang, 'Spiral in Houston'

Terra Incognita: Joshua Tree - Georgia Diva McGovern & Sebastijan Jemec, a film by Em Joseph, 2021.

NICHOLAS HALL - a day at the gallery

Documentation for J. Luca Ackerman

Documentation for J. Luca Ackerman

Off The Fence for CityGroup

Off The Fence for CityGroup

Off The Fence for Citygroup

Off The Fence for Citygroup

In The Studio with Karen Thomas for Nicholas Hall

In The Studio with Karen Thomas for Nicholas Hall

Growing Up With Art with Philippa Feigen for Nicholas Hall

Spiral in Houston for Frances Chang

Leeza Meksin, 2021

Leeza Meksin, 2021

Leeza Meksin, 2021



Ortega y Gasset Projects, 2021

Ortega y Gasset Projects, 2021

Lauren Portada, 2020

Lauren Portada, 2020

Lauren Portada, 2020

Georgia McGovern, 2020

Georgia McGovern, 2020

Georgia McGovern, 2020

Post-production for Emily Hass, 'Unwoven Series', Heinz Studio, MacDowell Colony, 2019.

Post-production for Emily Hass, 'Unwoven Series', Heinz Studio, MacDowell Colony, 2019.

Stills for 'Tallahassee' short film

Stills for 'Tallahassee' short film

Stills for 'Tallahassee' short film

Stills for 'Tallahassee' short film
info
/
1
2
3
4
5
6
7
8
9
10
11
12
13
14
15
16
17
18
19
20
21
22
23
24
25
26
27
28
29
30
31
32
33
34
35
36
37
38
39
40
41
42
43
44
45
46
47
48
49
50
51
52
53
54
55
56
57
58
59
60
61
62
63
64
65
66
67
68
69
70
71
72
73
74
75
76
77
78
79
80
81
82
83
84
85
86
87
88
89
90
91
92
93
94
95
96
97
98
99
100
101
102
103
104
105
·
·
·
·
·
·
·
·
·
·
·
·
·
·
·
·
·
·
·
·
·
·
·
·
·
·
·
·
·
·
·
·
·
·
·
·
·
·
·
·
·
·
·
·
·
·
·
·
·
·
·
·
·
·
·
·
·
·
·
·
·
·
·
·
·
·
·
·
·
·
·
·
·
·
·
·
·
·
·
·
·
·
·
·
·
·
·
·
·
·
·
·
·
·
·
·
·
·
·
·
·
·
·
·
·